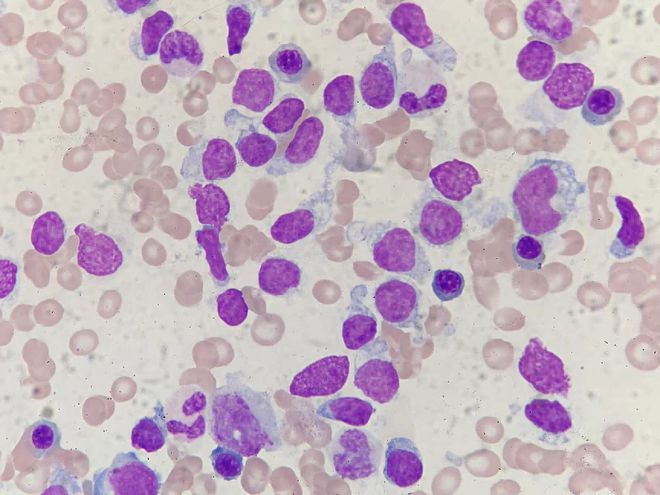
老年人如何科学补硒(老年人补硒的重要性)-硒宝网

老年人如何科学补硒(老年人补硒的重要性)
民生责编 徐丹美编 王澜201 4 年 4 月 15 日星期二民生·消费11A硒有什么神奇?硒是人体不可缺少的一种微量元素, 被医学界公认为“长寿元素”, 能强效祛除高血压、糖尿病、动脉硬化、脑中 风、冠心病、胃 肠病、肿瘤、肾虚前列腺、失眠、皮肤病、眼病、更年期综合症等多种慢性疾病, 有效抗击衰老、创造长寿奇迹?!窨怪琢鲋酰?研究证实, 硒不仅能够杀死人体肿瘤细胞, 还能够使致肿瘤物质无害化,每日补硒200 微克,肿瘤死亡率下降一半。●高血压、心脑血管的?;ど瘢?补硒能清除血管中的有害物质, 改善动脉硬化、消除脑血栓和心肌梗塞, 同时降低血压、血脂?!裉悄虿∫欢ㄒ刮?全新研究发现, 硒具有和胰岛素同样的功能, 也可以直接调节血糖、改善并发症及视力模糊。●给你一个新肝脏: 肝脏是人体重要的解毒器官, 而硒能够分解体内过多毒素、修复肝细胞。 肝病患者补硒后, 肝功能都会得到明显提升, 给你一个全新的健康肝脏?!袷咔崴伤?8 小时: 人体缺硒, 会造成失眠多梦、易 醒、记忆力减退, 服用硒尔康快速起效, 上床就能入睡, 而且睡眠质量高,精神格外的好?!穹缡遣〔辉偬郏?年龄的增加, 体内的硒流失严重, 稍有风寒, 颈肩腰腿就会疼痛难忍。

补点硒尔康, 多年的寒气都会被逼出体外, 颈椎病、肩周炎、老寒腿、关节炎等症都不易再犯。●皮肤顽癣好得快: 缺硒还会导致皮肤顽癣, 研究发现, 皮肤顽癣体内的血硒含量低于正常人, 补硒后会很快康复?!癜啄谡稀⑶喙庋劭辞辶耍?硒能提高眼睛里 GSH 酶的活性, 具有防治老花眼、白内障、青光眼的作用。 适当补点硒, 视力就有明显改善。 富硒区的长寿老人们, 个个眼不花?!裆鲂榍傲邢伲?很多中老年人一到 50 岁左右,就感觉自己不行了,排尿也困难了,这都是因为体内缺硒,肾、前列腺被过度氧化。 补点硒,立即排尿顺畅了, 而且整个人精力充沛!●调节免疫、抗衰老: 补硒可以清除人体“自 由 基”、提高免疫力, 具有抗病、抗衰老的功效。 这也是为什么富硒地区的长寿老人能高寿的根本原因。硒在人体内不能自己生成, 必需依靠外源性补充, 而我国大部分国土是缺硒区, 食物也是缺硒的, 单纯依靠食补是无法满足人体日常硒的需要量———200 微克。随着 “硒尔康”多年来的热销, 全国各地再次掀起了一股“补硒抗衰老”的浪潮。 用过“硒尔康”的人都说: “硒尔康”祛疾病、抗衰老的效果真的非常好。 比如:服用后几分钟: 肠胃 开始变得舒服, 精力得到提升。

使用初期:明显感觉到睡得好,胃口好, 大便畅通、小便畅快,精力充沛。其次:抵抗力迅速提高,腿脚有力, 气色变得越来越好。最后:五脏六腑通体舒畅, 白发返黑,皮肤容颜重现年轻。 血液, 血管变年轻了 , 高血压、心脑血管疾病、糖尿病、肿瘤、前列腺、失眠、色斑等相应的症状自 然消退, 身体由内 而外焕发生命活力,精力体力远远胜过同龄人,健健康康得长寿!选择华信牌硒尔康六大理由:⒈ 大品牌: 华信药业 30 年品牌历 练, 中国 硒制剂产业基地。⒉ 品质保证:医学权威专业机构科研成果。⒊ 安全:高科技纯生物制剂,无任何不良反应。⒋ 高含量:每100g中含硒3304mg。⒌ 易吸收:经生物工程转化的富硒酵母, 接近人体大分子的配位结构,生物利用率高、吸收充分。⒍ 多效产品:①抗肿瘤之王。 ②心脏守护神。 ③肝病天敌。 ④降粉能手。 ⑤明亮使者。 ⑥解毒专家。 ⑦抗衰老。 ⑧男性体内黄金。 ⑨胃肠道养护专家。 ⑩是可以直接抗病毒的营养素。从头到脚少生病科学补硒,享受补贴! 如果您患有高血压、糖尿病、动脉硬化、脑中风、冠心病、胃肠病、肿瘤、肾虚前列腺、失眠、皮肤病、眼病久治不愈, 现在打进电话就可以享受买硒尔康送硒维康的大型优惠活动,名额有限送完即止!抢购热线:前 300 名打进电话, 现还可享受买硒尔康补贴硒维康!北京教授发现 “长寿元素”医学界专家罗大珍教授说: 生活压力、防腐剂、化学剂的滥用等, 未来十年,因为健康问题中国大约 1/3 的家庭可能将耗尽所有的积蓄! 到底是谁偷走了我们的健康? 到底是什么在吞噬着我们的健康?从秦始皇到现代人, 从广西巴马到江苏如皋, 长寿一直是人们追求和研究的目标。
为什么有地方的人能活到 90 岁少生病,100 岁不显老! 而有些地方的人, 却高血压、糖尿病、心脑血管病高发,年仅 50、60尿病、心脏病、脑血栓、肝炎、皮肤病、眼病吃药一箩筐 不如补点硒尔康岁就突发急??!透过种种迷雾、猜测,我国医学权威科研机构通过十几年的严谨研究, 终于发现了神奇而科学的 “长寿元素”。我国有很多 “长寿之乡”, 比如广西的巴马、江苏的如皋、河南的夏邑、广东的三水……我国医学科研机构对此展开了长期、深入的研究, 这些闻名全国、享誉世界的长寿之乡有一个共同的现象:高血压、糖等症的发病率很低,很多居民长年不生病、不吃药,也没有一个大胖子。进一步研究发现, 在广西的巴马、江苏的如皋的水土、大米、果蔬、茶叶里都检测出硒含量大约为 55 微克/ 100 克, 是全国平均水平的 5 倍多! ( 全国水平 8-10 微克/ 100 克)。而这些长寿之乡 的百岁老人头发、血液中的硒含量, 也 高于全 国 平均 水 平3—5 倍, 这些百岁 老人极少是心脑血管疾病及肿瘤患者, 身体硬朗、思维清晰、视力也很好。经我国众多医学科研机构综合研究发现,在中国少数的富硒地区,人们普遍都长寿, 高血压、心脑血管病、糖尿病、肿瘤、肝病的发病率非常低。

而在中国缺硒地带,高血压、心脑血管病、糖尿病高发, 肿瘤连年增多, 患肝炎的人居高不下。 严重缺硒的地区还会高发一种叫 “克山病”的心肌?。∥蠢词甑慕】滴;?,你打算如何应对?探寻中国长寿之乡的秘密如皋的萝卜 巴马的水里都含硒科学证实:长寿之乡都是 “富硒区”重新剪裁拼接、挖补粘贴 假币有了部分防伪特征半真半假变造币蒙过验钞机提醒您:机器验完后用手再检查钞票2000 元验钞机没验出假币在武汉开公司的张女士反映,一年前,公司买了几台 “中钞信达”的验钞机, 每台花费 2000 多元。 当时验钞机卖家信誓旦旦,假如验钞机验的是真钱,银行检验为假钱,损失由卖家承担。 可近日,张女士去银行存钱,却被验出是假钞,银行工作人员根据规定,将其没收。记者就此事联系到卖家,对方说,他们专门就此事找到了相关银行, 发现该假币属于无缝粘贴假币,一面是真的,一面是假的。当场用自带的验钞机检验,第一次没有验出,第二次却验出是假币?!罢馐粲诒湓毂?。 ”人民银行武汉分行相关负责人告诉记者,假币通常分为两类:一类是伪造币,一类是变造币。伪造币整张都是假的,变造币除了拼接纸币外,还有全真纸币、挖补变造币、两面揭变造币等多种形式,比如对多张真币剪裁重新拼接,9 张变 10 张, 挖补变造币指将真币上的变色荧光数字挖出来再粘贴到假币上, 它们具有真币的部分防伪特征, 有时会骗过普通验钞机。

“我们用的点钞机,每次都要正反过两遍,厂家有技术上的升级也会通知我们。 ”沿江大道一家文化公司的会计说道, 目前还没有发现假币。不同验钞机技术各不同变造币为何能骗过市民手中验钞机,却骗不过银行的验钞机?记者在汉口建设大道一处办公用品商店看到,验钞机从 780 元到 2400 元不等,工作人员强烈推荐最贵的全智能验钞机?!?80 元的机器, 一年偶尔拿来用用, 点钞还可以。 平常使用较多的话, 还是建议2400 元的这种机器,机芯不一样价格也不一样。 ”工作人员介绍。 在某大型电商网站上, 验钞机价格从 200 元到 3 万多元不等?!澳壳耙泄裉ㄊ褂玫亩嗍?A 类验钞机,具有 9 种及 9 种以上鉴别技术。 ”人民银行武汉分行相关负责人解释, 验钞机根据人民币的防伪特征, 如冠字号码、油墨、安全线等做出相应的识别功能, 银行都要根据人民银行要求采购相关设备, 并与厂家签订售后服务协议, 厂家要提供后期维护, 如针对新的伪造技术进行技术升级等等,每台机器设备价格都在 5000 元以上,好的上万元?!笆忻嫔鲜褂玫亩嗍?B 类, 甚至是 C类验钞机, 鉴别技术缩减到 5 种甚至 4种。 ”该负责人说,个别厂家针对个体购买使用者也没能提供后期的升级维护服务。
“不管是哪一类验钞机, 都是被动检验,针对人民币的防伪特征检验。但银行的清分机, 如存取款一体机, 是主动检验, 即使是放张纸进去,机器都会对它进行紫外、红外全方位扫描,检验结果也更准确。 ”该负责人介绍。验两遍也不一定识别准真假普通市民应该如何识别变造币等高仿真假币呢?上述人行相关负责人介绍,普通的验钞机可能过两遍也检验不出高仿真假币,市民机器验过之后,还应配合人工检验?!把槌柿坑胁畋?, 长期使用后, 灵敏度也会下降, 再加上没有针对市面上新出现的制假变造技术来升级应对, 这些都会导致验钞机不灵。 ”人行相关人士提醒,验钞机验过之后, 除了观察水印、油墨、图案、文字和安全线之外,用手再点一遍看手感,手持钞票用力抖动听声音,真钞有清脆响声。记者马辉 宋丹丹 通讯员张珊珊钞票在市民手中的验钞机上蒙混过关, 但却被银行的验钞机给揪了出来, 这究竟是为什么 ?市 民 该 如 何 应对?2014-04-14 22:32
继续阅读
- 暂无推荐
